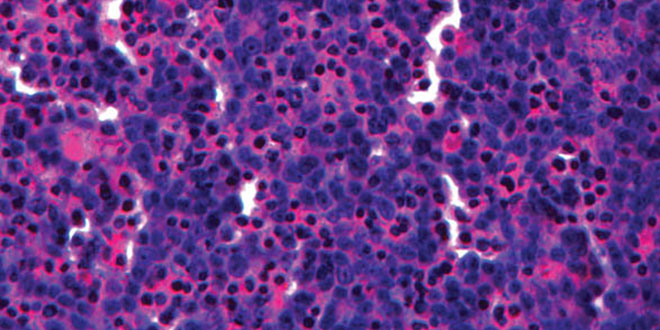

Un rein imprimé en 3D pour tester les médicaments de demain

L’Université du Queensland, située en Australie, est une des universités les plus à la pointe sur la recherche en bio-printing au niveau mondial et c’est naturellement qu’elle annonce aujourd’hui s’être rapprochée de la compagnie américaine Organovo, qui s’est fait connaître ces derniers mois pour ses travaux sur la bio-fabrication de cellules de foie.
Cette collaboration aura pour but de mettre au point un premier rein imprimé en 3D et sera menée par le professeur Melissa Little de l’Institut de Bio-Science Moléculaire de l’Université du Queensland. Ces premiers reins pourraient notamment permettre de tester dans des conditions proches de la réalité la toxicité de certains traitements médicaux.
En début d’année, la société Organovo, basée à San Diego, annonçait avoir imprimé en 3D les premières cellules de foie humain
« Si nous pouvons tester la toxicité des médicaments sur les reins avant même de le tester sur l’homme, nous pourrions gagner beaucoup de temps, d’efforts et d’argent » explique Melissa Little avant d’indiquer que le but ultime serait bien évidemment de pouvoir imprimer des reins en vue d’être transplanté sur des humains, « il y a encore du travail pour y arriver mais une fois prêt cela pourrait sauver des vies et réduire largement le coût de certains traitements. »
Selon Ian Walker, responsable des pôles Science, IT, Innovation et Arts de Queensland, le gouvernement australien a supporté les recherches du Professeur Little à hauteur de 1 million de dollars, et y voit un intérêt majeur dans les années à venir, « 1/3 des australiens sont susceptibles de développer une maladie chronique du rein, c’est pourquoi les recherches du Professeur Little sont très importantes ».
Retrouvez notre article sur le bio-printing rédigé en début d’année ICI. Photos PrioriteSanteMutualiste / Organovo.
Pour rester informé abonnez-vous à notre flux RSS ou pages Facebook et [follow id= »3dnatives » ]







[…] son premier produit, des tissus de foie humain imprimés en 3D, utilisés notamment par les laboratoires pour tester leurs médicaments. L’année prochaine, elle devrait proposer des tissus imprimés en 3D capables de répliquer […]
[…] les applications de cette technologie sont nombreuses, comme la possibilité de tester des cosmétiques et des produits pharmaceutiques, réduisant ainsi les expérimentations sur les animaux, mais aussi la création de médicaments […]